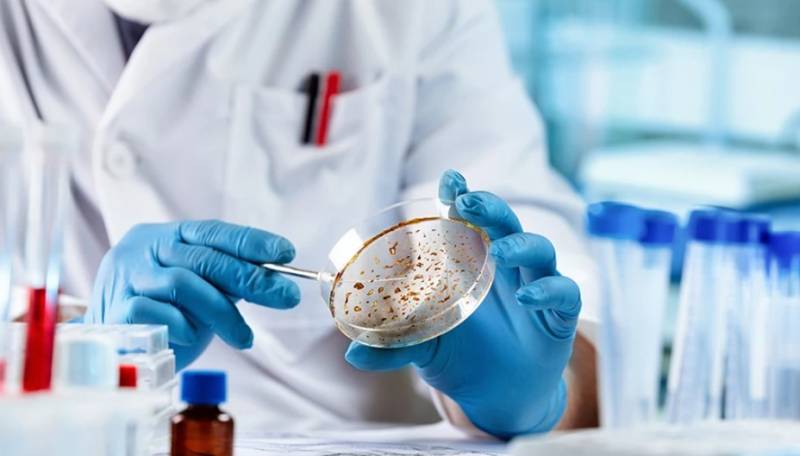
Ανθρώπινο DNA: Εμφανίστηκαν 155 νέα γονίδια

Περίπου 155 νέα γονίδια έχουν εντοπιστεί, τα οποία ξεπήδησαν αυθόρμητα (de novo) από μικροσκοπικά τμήματα στο ανθρώπινο DNA και μερικά από αυτά τα «μικρογονίδια» φαίνεται πως σχετίζονται με ανθρώπινες ασθένειες, σύμφωνα με μία νέα μελέτη με επικεφαλής έναν Έλληνα ερευνητή.
Οι επιστήμονες, με επικεφαλής τον Νικόλαο Βακιρλή του Ερευνητικού Κέντρου Βιοϊατρικών Επιστημών «Αλέξανδρος Φλέμινγκ» στη Βάρη, οι οποίοι έκαναν τη δημοσίευση στο περιοδικό Βιολογίας «Cell Reports», δημιούργησαν ένα «οικογενειακό δένδρο» που συγκρίνει τους ανθρώπους με άλλα 99 είδη σπονδυλωτών ζώων, όπως οι γορίλες, οι χιμπατζήδες, τα άλογα, οι αλιγάτορες κ.ά. Χρησιμοποιώντας υπολογιστικές τεχνικές οι ερευνητές γύρισαν προς τα πίσω το εξελικτικό «ρολόι» αναφέρει το ΑΠΕ-ΜΠΕ.
Ξεπηδούν από τμήματα του DNA που δεν κωδικοποιούν πρωτεΐνες
Παρακολουθώντας, έτσι, τη διαχρονική ανάδυση νέων γονιδίων, βρήκαν 155 που εμφανίστηκαν από το «πουθενά» (de novo) και όχι από το προϋπάρχον γονιδίωμα (με τη συνήθη διαδικασία των μεταλλάξεων). Τα de novo γονίδια ξεπηδούν αυθόρμητα από τμήματα του DNA που δεν κωδικοποιούν πρωτεΐνες, αλλά στη συνέχεια τα ίδια κωδικοποιούν μικροπρωτεΐνες. Μερικά από αυτά τα 155 τελείως νέα γονίδια στο ανθρώπινο γονιδίωμα είναι αρχαία και χρονολογούνται από την περίοδο καταγωγής όλων των θηλαστικών, ενώ άλλα εμφανίστηκαν πολύ πιο πρόσφατα, σύμφωνα με τη μελέτη.
Από αυτά τα 155 νέα γονίδια, τουλάχιστον τα 44 φαίνεται να σχετίζονται με την κυτταρική ανάπτυξη και την υγεία του οργανισμού. Η μελέτη των ερευνητών αναφορικά με τον ρόλο τους σε ασθένειες οδήγησε στο συμπέρασμα ότι, μεταξύ άλλων, τρία από αυτά σχετίζονται με παθήσεις όπως η μυϊκή δυστροφία, η μελαχρωστική αμφιβληστροπάθεια των ματιών και το σύνδρομο Alazami. Ένα άλλο νέο γονίδιο σχετίζεται με τον ιστό της ανθρώπινης καρδιάς.
«Θα είναι πολύ ενδιαφέρον σε μελλοντικές μελέτες να κατανοήσουμε τι μπορούν να κάνουν αυτά τα μικρογονίδια και κατά πόσο μπορεί να εμπλέκονται άμεσα σε κάποια ασθένεια», δήλωσε ο κ. Βακιρλής. Όπως ανέφερε στο Live Science, «βρήκαμε ότι δύο από αυτά αφορούν αποκλειστικά τους ανθρώπους», δηλαδή δεν έχουν εμφανιστεί στο γονιδίωμα άλλων ζώων.